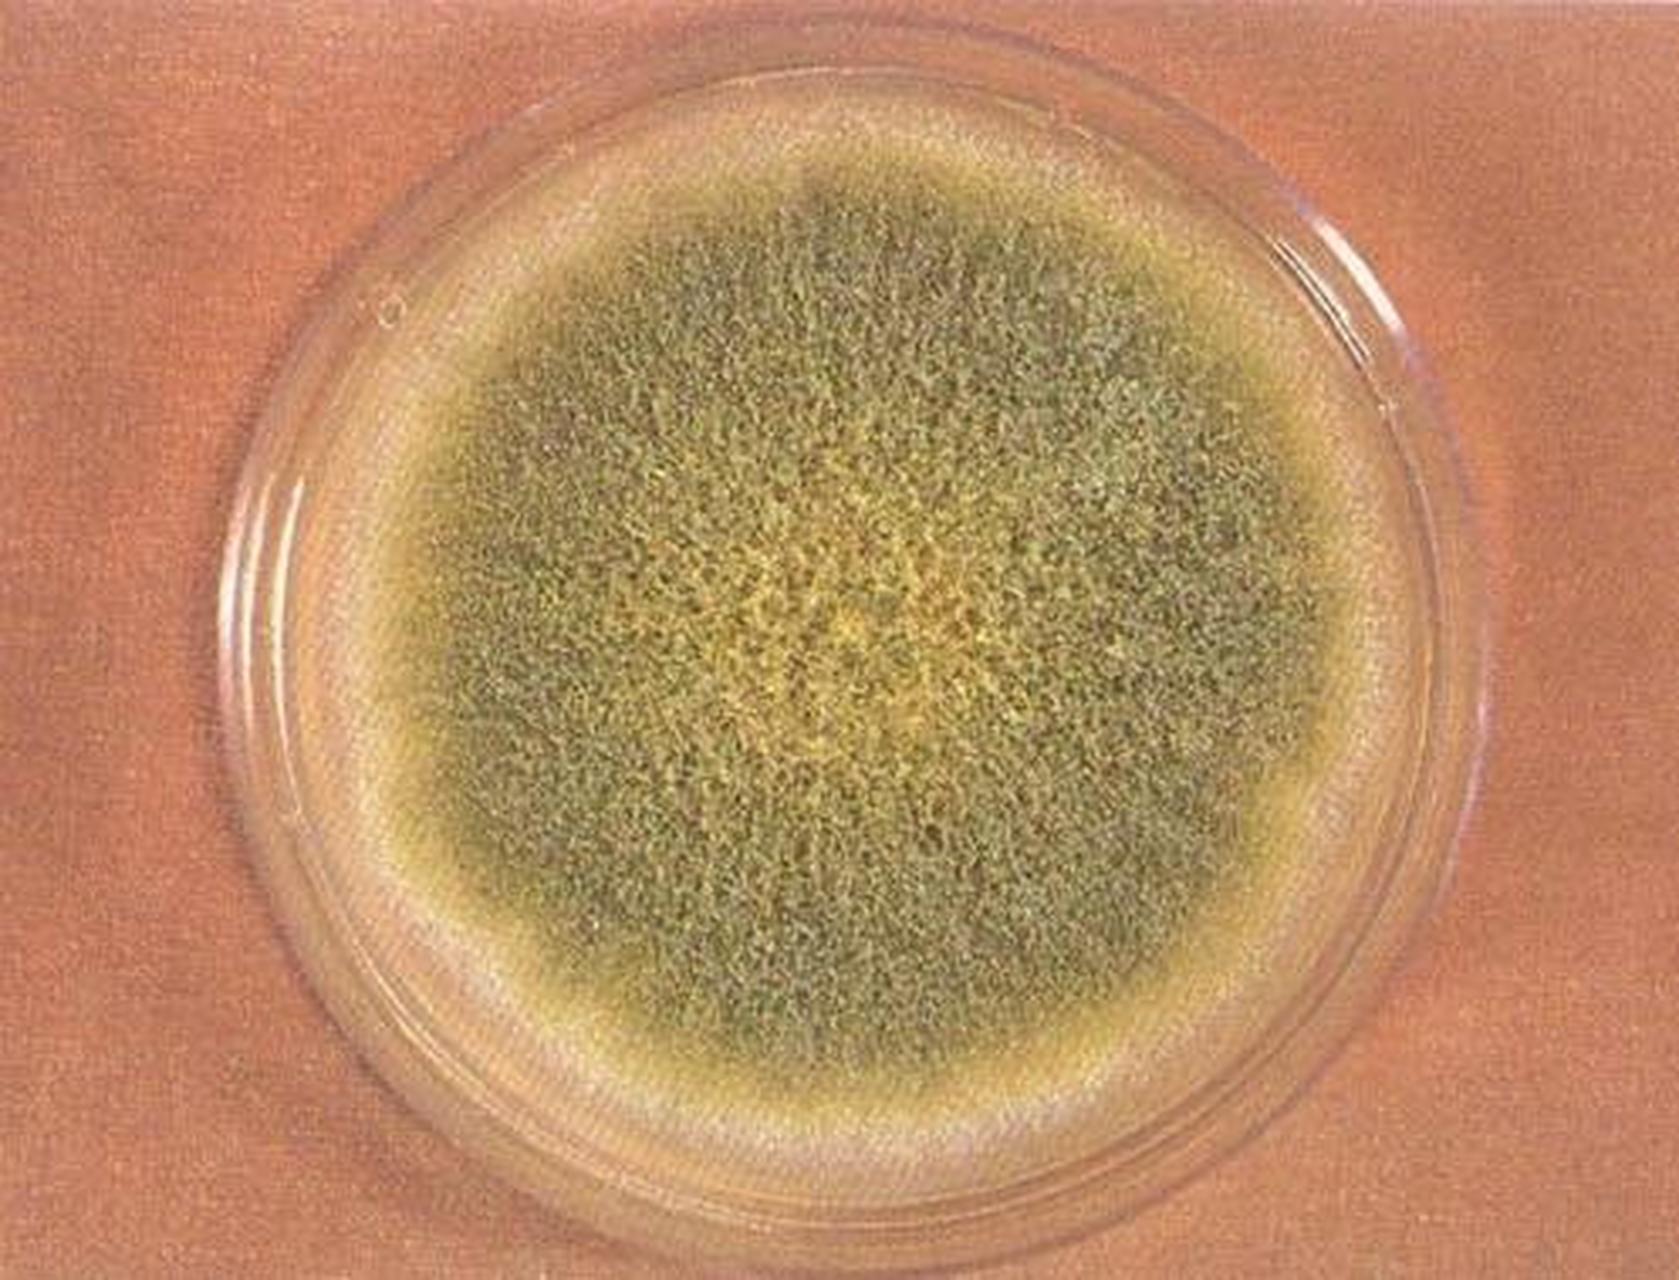
身边的超级致癌物黄曲霉菌#  你可能听说过黄曲霉素,它是一种毒性极

黄曲霉菌

揭秘超级致癌物:黄曲霉菌,你身边的潜在健康威胁!
图片尺寸640x960
身边的超级致癌物——黄曲霉菌!
图片尺寸640x427
揭秘黄曲霉菌:隐藏在食物中的"致癌杀手"
图片尺寸640x427
黄曲霉菌
图片尺寸1200x900
【关注】超级致癌物黄曲霉菌?专家解读
图片尺寸599x600
黄曲霉菌喜潮湿食物表面发霉坚决扔掉
图片尺寸640x427
揭秘黄曲霉菌:隐藏在食物中的"致癌杀手"
图片尺寸640x427
黄曲霉毒素
图片尺寸1024x768
的毒素是不可能洗掉的,发霉的食物,携带一种超级致癌物,叫黄曲霉素
图片尺寸1000x750
警惕你身边的超级致癌物——黄曲霉菌的产生,危害与预防清除
图片尺寸640x480
黄曲霉素主要存在于什么食物中食物中常见3种一类致癌物
图片尺寸4200x2800
身边的超级致癌物黄曲霉菌# 你可能听说过黄曲霉素,它是一种毒性极
图片尺寸1679x1280
提到霉菌毒素,就不得不提到 黄曲霉毒素,它是最常见,最具毒性和研究
图片尺寸641x805
黄曲霉棉兰染色×1000 培养特征:黄曲霉菌在 sda 及 pda 培养基上25
图片尺寸1282x1280
高温能杀死黄曲霉素吗
图片尺寸640x337
消去黄曲霉素有哪些窍门
图片尺寸683x424
甚至有些人说黄曲霉素比砒霜毒性强68倍,比氰化钾强10倍,即使沾上一点
图片尺寸622x379
【健康养生85】黄曲霉菌,人类健康杀手!冰箱冷藏食物不再安全了吗?
图片尺寸674x421
冷冻食物产生黄曲霉菌吗(冷冻的鸡翅不能吃)(3)
图片尺寸640x427
黄曲霉素主要存在于什么食物中(2)
图片尺寸555x319